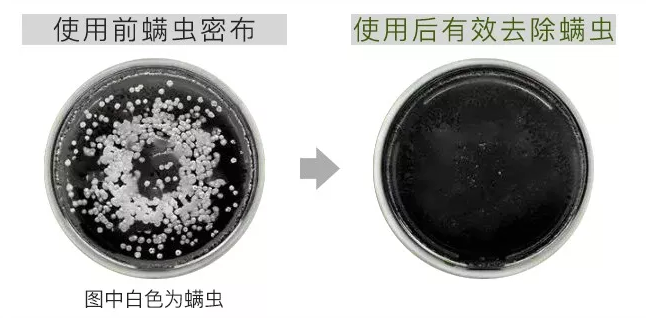

不用染不用烫,7天发量多了,28天白发黑如墨!洗洗头就能年轻2O岁!
2021年12月29日
判断一个人的年龄,无非就看两点:










何首乌+黑芝麻,30天头发黑如墨













防脱固发,4周时间发量暴增










去屑止痒,消灭头皮10万螨虫

广告
30阅读
0赞
乐活好货馆

